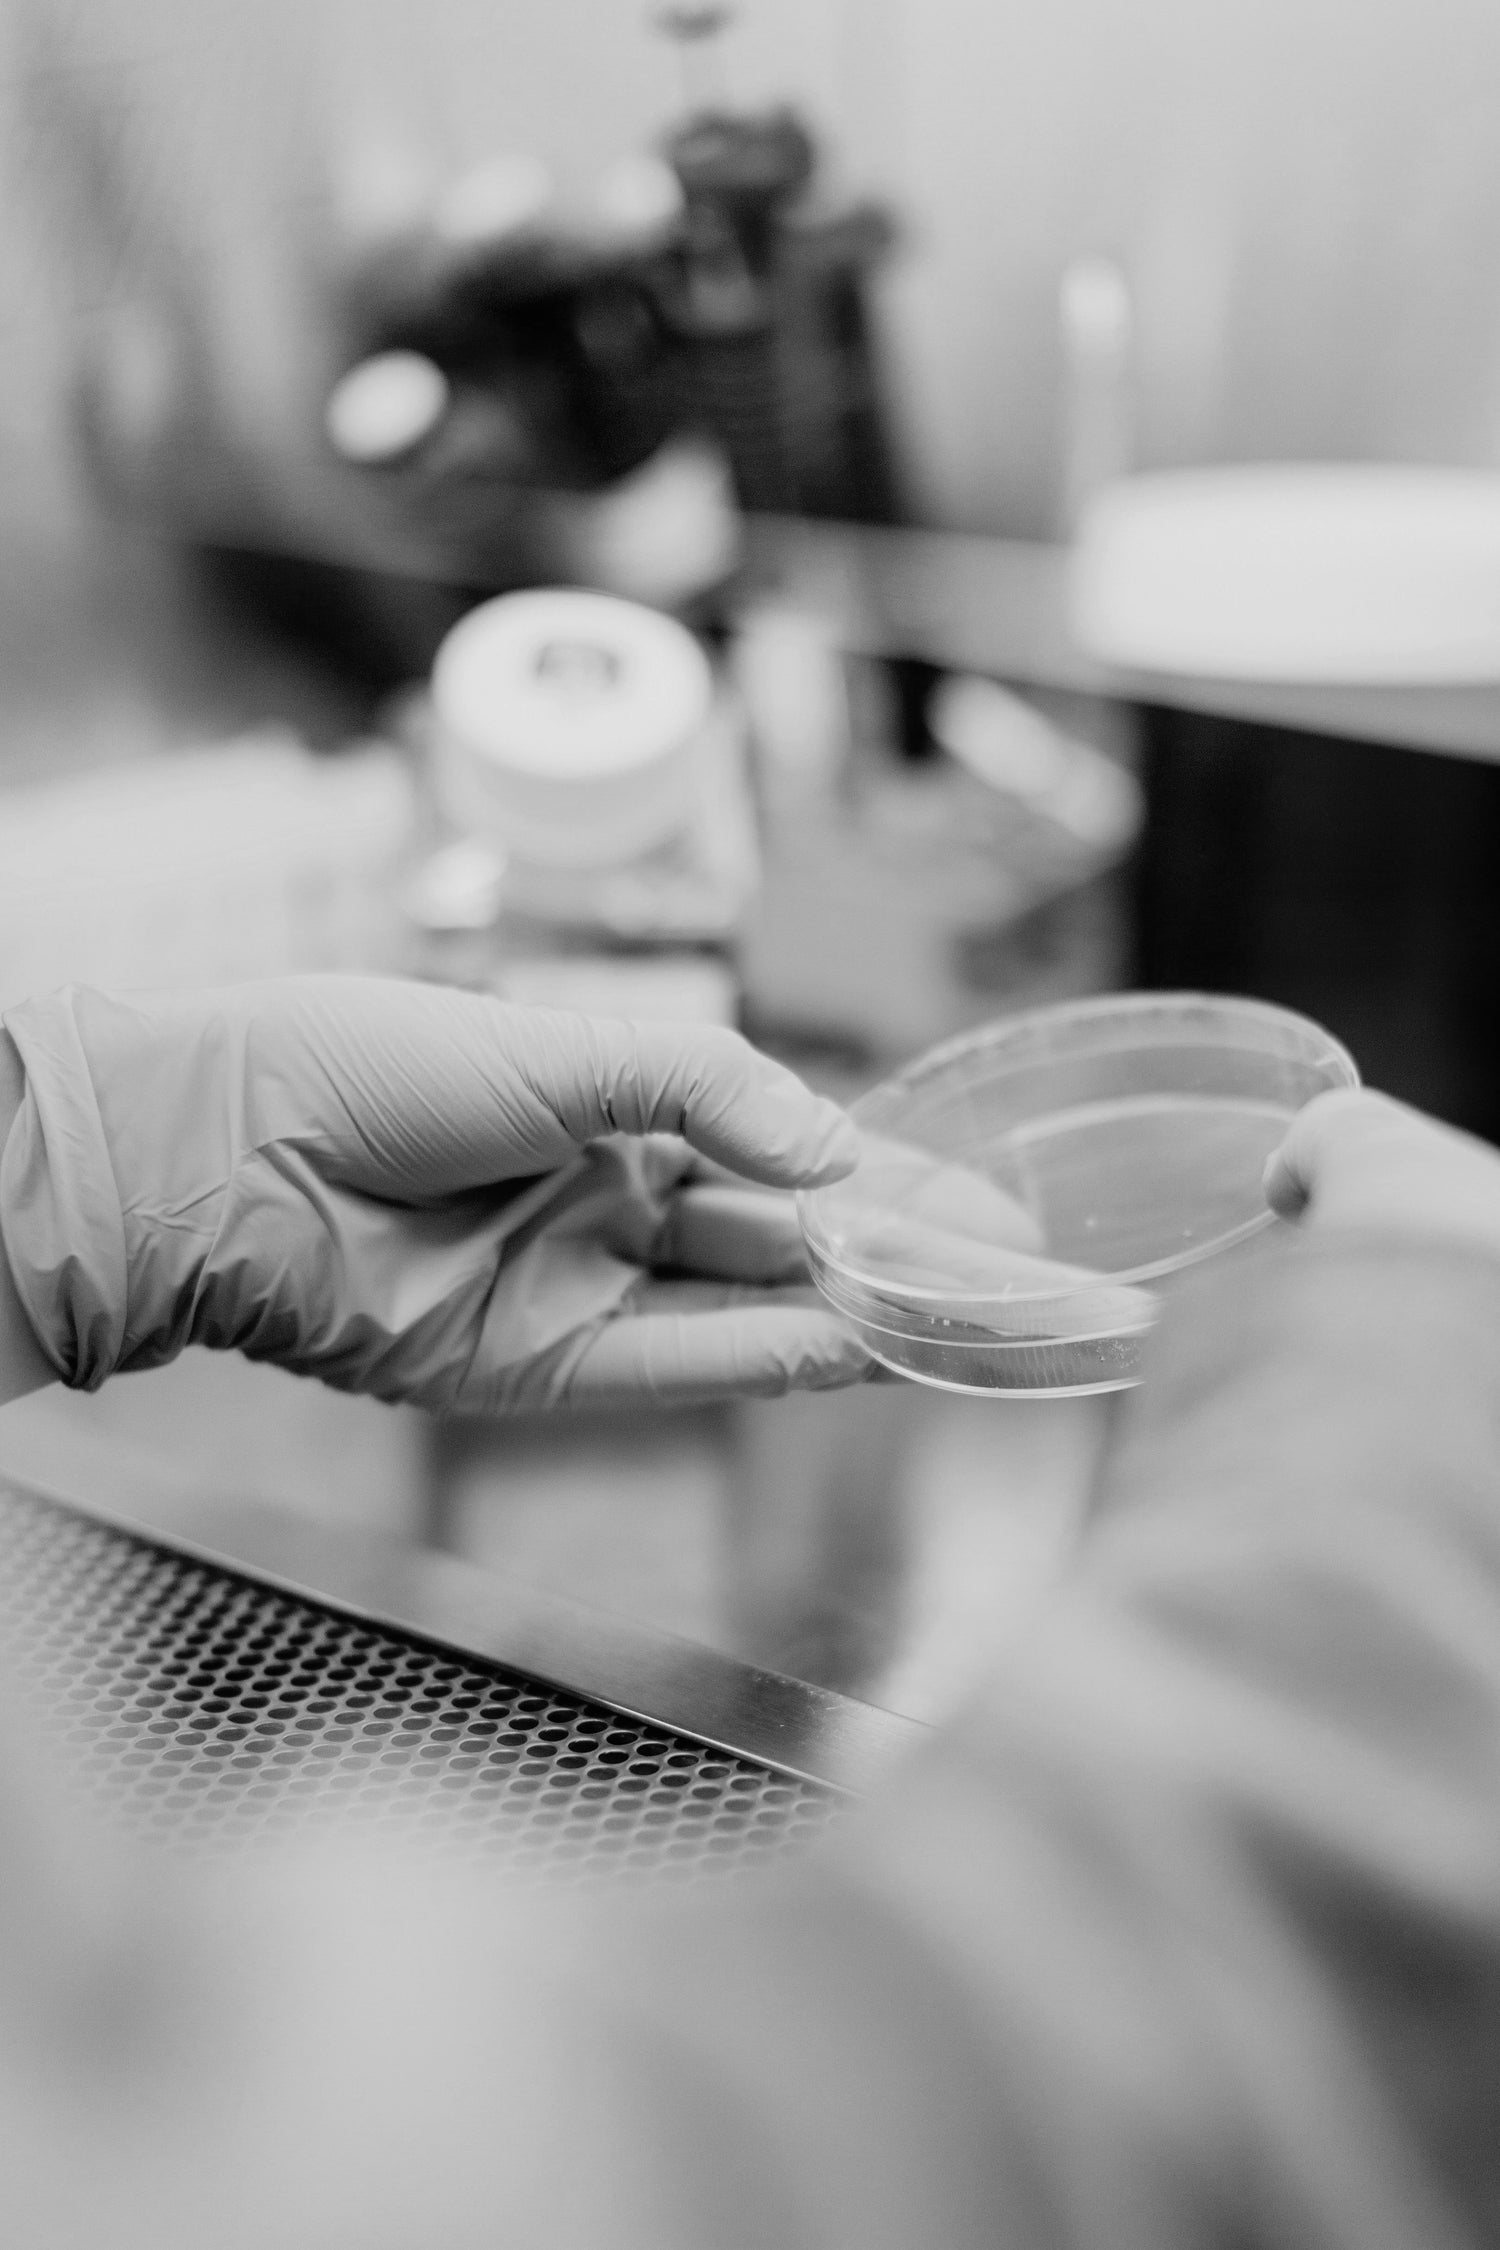

RECOMMENDED FOR YOU
-
ISO-LOCK™️ - LIP PRIMER & TOP COAT
Regular price From £14.99 GBPRegular priceUnit price / per -
Adapt X™ - Colour Changing Cheek and Lip OIl
Regular price £11.00 GBPRegular priceUnit price / perSold out -
Pigment 7™ - Pigmented Lipgloss
Regular price £10.99 GBPRegular priceUnit price / per -
Sold out
Bubblegum Pink Lip Gloss Set
Regular price £25.00 GBPRegular priceUnit price / perSold out -
Sold out
The Soft Spectrum Gloss Palette
Regular price £39.00 GBPRegular priceUnit price / perSold out
The Science Of Beauty
“The Science of Beauty" is an educational series created and hosted by Jadene Taylor, the founder and cosmetic scientist behind Jadene Cosmetics. This series delves into the ingredients, benefits, and functions of our cosmetic products, providing a deeper understanding of what makes them effective.
Join Jadene as she enlightens, educates, and empowers you with the knowledge to make informed beauty choices. Get ready to discover the true science behind beauty!

About us
Welcome to Jadene Cosmetics, where luxury meets innovation in every product. Founded by Jadene Taylor, a Pharmaceutical and Cosmetic Science graduate, our brand is dedicated to creating high-quality, science-backed beauty essentials. Dive into our story to discover how we're redefining beauty norms and celebrating diversity with products designed for every skin tone and type.